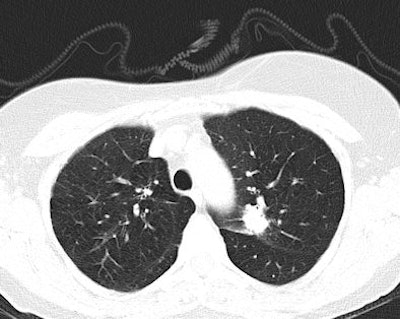
Above: CT scan of lung cancer nodule in left upper lobe in lung window. Below: CT scan of the same lung cancer nodule in left upper lobe in mediastinal window. Images courtesy of Dr. Marlies Heuvers.

An eminent group of researchers has stressed the need to avoid getting too carried away with the potential benefits of lung cancer screening with CT. They have struck a decidedly cautious note in a commentary published online on 8 August by the European Journal of Epidemiology.
Early detection of lung tumors by lung cancer screening programs has led to more curative therapeutic options for patients and a mortality reduction of 20%, so there can be no doubt about the importance of such programs, noted lead author Dr. Marlies Heuvers, from the department of respiratory diseases and tuberculosis at Erasmus Medical University Center in Rotterdam, the Netherlands. But results from the National Lung Screening Trial (NLST) may only apply to individuals with access to high-quality lung cancer care, and screening trials only include a minority of lung cancer patients as most people do not comply with these criteria.
"Therefore, clinicians should be cautious in generalizing findings to the total population of smokers and take into account that the use of lung cancer screening in clinical practice may have limitations in reducing lung cancer mortality," Heuvers stated.

Lung cancer is the major cause of cancer-related death in both men and women worldwide, and the five-year survival is only 16%. Early stages of lung cancer have a better prognosis, so early diagnosis of lung cancer could lead to a reduction of lung cancer mortality, the authors wrote.
The NLST has shown that lung cancer death rates can be reduced by 20% when a high-risk group is screened with a low-dose CT scan compared with chest radiography. The participants were asymptomatic persons ages 55 to 74 who had smoked at least 30 pack years in their lifetime. Participants received a baseline CT scan and two annual screening CT exams, and were then followed for a median of 6.5 years. Screening of high-risk individuals led to a better opportunity for curative treatment, the investigators found.
"There are many potential advantages of CT screening," Heuvers pointed out. "Low-dose CT is not only a valuable tool to detect lung cancer at earlier stages, it can also be used to monitor other causes of morbidity and mortality in heavy smokers, such as ischemic heart disease and chronic obstructive lung disease (COPD). Early detection of coronary artery calcification could be used to identify patients who are likely to experience ischemic heart disease. In addition, early detection of COPD could signify patients with a rapid progression of their COPD, leading to an intensive treatment."
Screening for other causes of morbidity and mortality in heavy smokers might increase the cost-effectiveness of screening programs, especially if positioned in multidisciplinary programs that provide smoking-cessation programs. CT scans can play an important role in research to understand the etiology and pathophysiology of COPD, she added.
However, major concerns in lung cancer screening are the management of false-positive findings and the impact of overdiagnosis. Up to 20% of screening tests lead to false-positive findings, and this exposes participants unnecessarily to potentially harmful diagnostic evaluations and psychological discomfort, according to Heuvers. Between 10% and 25% of screen-detected lung cancers may be overdiagnosed cases, and it is difficult to predict which early-stage cancers will ultimately progress and cause the death of a patient.
"Another important issue that has not been clarified following the results of the NLST is related to the generalizability of its results to the general population, as most trials use very strict inclusion criteria and thereby select only a subset of the individuals. At a population level, the observed mortality reduction in the NSLT may vary depending on certain factors," she stated.
The impact of screening will be decreased in countries with a population with a lower susceptibility for lung cancer. Moreover, expensive high-quality CT scans are only available in developed countries, and the assessment and interpretation of scans depend on the quality of the radiologist, yet there is a large difference in the quality of education of medical doctors, according to the authors.
Also, screening programs may unintentionally give the reassurance that there is no need to stop smoking, leading to continuation of smoking, and the cost-effectiveness of low-dose CT screening must be considered. The use of three annual CT screenings, the follow-up of the participants, and the additional clinical procedures in response to positive screening are very expensive: $725,000 (about 560,000 euros) to prevent one death from lung cancer, they concluded.